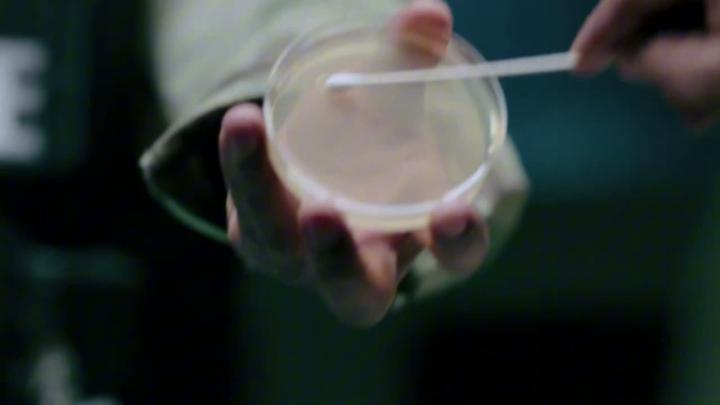
️Стартовал сериал от автора «Во все тяжкие» и «Лучше звоните Солу» Винса Гиллигана — «Из многих»

️Стартовал сериал от автора «Во все тяжкие» и «Лучше звоните Солу» Винса Гиллигана — «Из многих»
Сюжет: весь мир поразил вирус счастья и оптимизма, но один человек устоял. Это писательница Кэрол Стурка из Альбукерке. Теперь остальные хотят «вылечить её», хотя это они больны — в городе творится сущий кошмар.
Уже вышли первые 2 серии. Ждём остальное уже скоро.